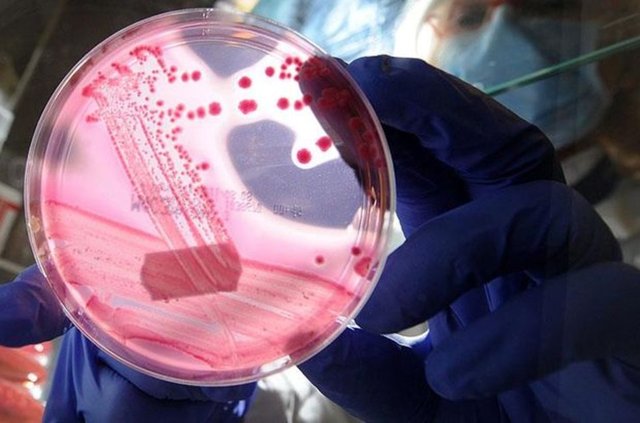

Aile dizimi nedir, ne anlama gelir? Aile dizimi ne demek?
Aile dizimi günün hakkında en çok araştırma yapılan konulardan biri durumunda. Konuya ilişkin vatandaşlar; aile dizimi nedir, ne anlama gelir ve ne demektir aramaları yapıyor. İşte aile dizimi ile ilgili bilinmesi gerekenler...

Alman psikoterapist Bert Hellinger'in psikoterapi yöntemlerinden biri olan aile dizimi ile ilgili merak edilen soruların cevaplarını bir araya getirdik. Peki, aile dizimi nedir? İşte detaylar...
AİLE DİZİMİ NEDİR?
Aile Dizimi, Alman psikoterapist Bert Hellinger tarafından ortaya atılan psikoterapi yöntemidir. Terapinin çıkış noktası her birimizin, hem de kuşaklar öncesinden başlayarak, ailemizdeki her birey ile bir bağımız olduğudur. Yani yetişkinler olarak bugün aldığımız her doğru-yanlış karar, olumlu ya da olumsuz davranışlarımız, sorunlarımız veya korkularımız aslında atalarımızdan mirastır. Aile içinde yaşanan her durum aile fertlerinin DNA’larına kazınmakta ve nesilden nesle aktarılmaktadır.

BAZI SORUNLARIN KAYNAĞI AİLE DİZİMİNE DAYANIYOR
Aile, arkadaş ya da sevgililik ilişkilerinde, istemeden, kişi/kişilerden ‘kaçma’, ‘bağlanamama’ gibi anlamlandırılamayan durumlar, aile dizimi ile analiz edilmektedir. Aile dizimi ile bu sorunun temeline inilmekte ve sorunun kaynağı araştırılmaktadır. Bu ‘kaçma’ halinin atalardan miras olup olmadığı, aile dizimi ile öğrenilebilmektedir.
Örneğin bir danışanın büyük büyük dedesinin canını kurtarmak için savaştan kaçtığı ve o kaçma halinin de genetik miras olarak, davranış biçimi şeklinde danışana miras kaldığı bu yöntemle öğrenilebilmektedir.
